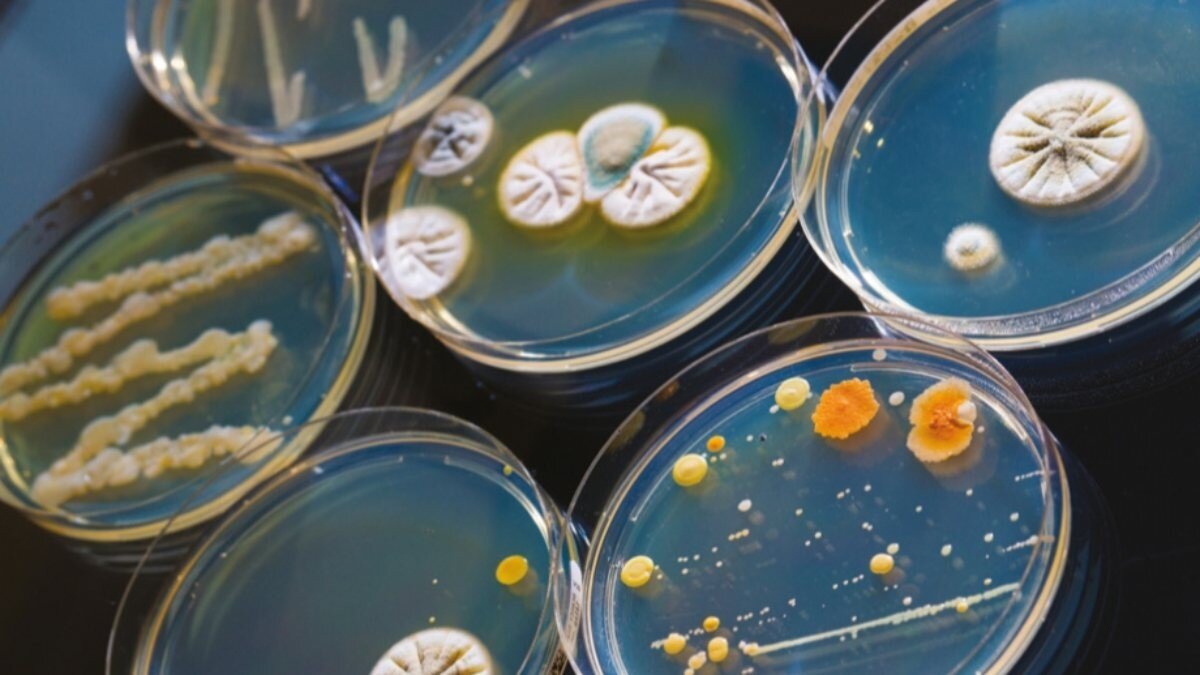

Bağırsakta bulunan ve mikrobiyota şeklinde isimlendirilen bakteriler, bir anlamda ikinci beyin olarak görülür. Mikrobiyota bakterileri gıdaların sindirimi noktasında önemli bir işleve sahiptir.
İnsan mikrobiyotaları; bakteri, virüs ve mantarlar dahil olmak üzere trilyonlarca hücreden oluşur ve kendi hücrelerimizin on katından fazladırlar.
En büyük mikrobiyota topluluğu bağırsaklarımızda bulunur. Diğer önemli yaşam alanları cildimizdir.
Mikrobiyal hücreler doğuştan gelen bir ilişki ile bizlerle birlikte yaşarlar ve sağlıklı olmamıza yardımcı olurlar. Böylece fırsatçı mikroplara karşı bizi korurlar.
Bağırsak florası olarak bilinen sindirim sisteminin içinde yaşayan mikroorganizmalar her bir kişi için benzersizdir ve yaklaşık 2 kilogram civarındadır.
Mikrobiyota, beslenme, bağışıklık, beyin ve davranış üzerindeki etkileri açısından önemlidir. Mikroorganizmaların normal dengesi bozulduğunda çok sayıda hastalık ortaya çıkar.
MİKROBİYOTALARIN ÖNEMİ
Birlikte yaşadığımız ve insan yaşamının böylesine ayrılmaz bir parçasını oluşturan mikroorganizmalar sağlığımız üzerinde bir dizi rol oynar.
Araştırmalar vücudumuzdaki mikroorganizma popülasyonları ile aşağıdaki hastalıkların arasındaki bağlantıları bulmuştur:
Astım Otizm Kanser Çölyak hastalığı Kolit Diyabet Egzema Kalp hastalığı Yetersiz beslenme Skleroz Obezite
MİKROBİYOTA TESTİ
Metabolik açıdan mikrobiyotaların çok önemli bir yeri vardır. Bunlar düzenli olarak testlerden geçirilmeli ve kontrol edilmelidir.
Obezite ya da kanser gibi çok ciddi rahatsızlıkları tetiklemesi adına bu testlerin zamanında yapılması kurtarıcı bir role sahiptir.
Bu test için dışkı örneği alınır. Bu yöntem mikrobiyotonanın tüm haritasını çıkarır. Özellikle bağırsak kanseri yapan mikroorganizmaların olup olmadığı analiz edilir. . 



